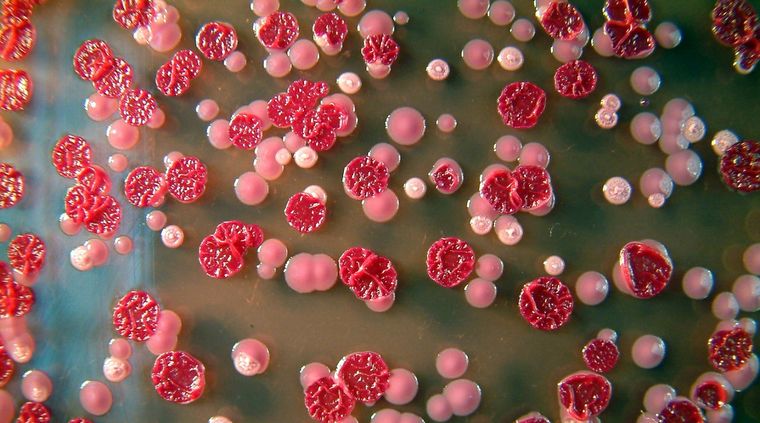
Melioidosis. Foto: joya.life

Hallan un brote de una rara enfermedad tropical peligrosa en 3 estados de USA
Son tres estados de los Estados Unidos de Norteamérica que no limitan entre sí.
Te puede interesar
Trump llamará a Netanyahu para pedirle que no responda a los ataques de Irán
El dato es relevante, porque han aparecido casos de una enfermedad rara y, al no haber adyacencia entre ellos, puede que los casos sean muchos más.
La enfermedad en cuestión es más de zonas tropicales. Se llama melioidosis o enfermedad de Whitmore y ya hay un contagiado muerto en este país.
Normalmente, se la halla en el sur de Asia, particularmente en India, y en el norte de Oceanía, noroeste de Sudamérica y sur de Centroamérica.
Nunca ha habido un caso en Norteamérica. Nunca hasta ahora, que hay ya 3 casos.
Rara
En EEUU hay ya una alerta sanitaria emitida por los Centros para el Control y la Prevención de Enfermedades de esa nación.
Los casos se rastrean desde marzo y son 3 hasta ahora las contagiadas en estados no adyacentes.
Los enfermos viven en Minesota, Kansas y Texas.
A la extraña enfermedad tropical que tiene el nombre de melioidosis, algunos la llaman enfermedad de Whitmore.
La bacteria
Un paciente infectado, con malestares pulmonares y hepáticos preexistentes, murió en el hospital, 10 días después de ser internado. En mayo, además, hallaron dos pacientes, una mujer y un niño. Uno de ellos sigue en el hospital.
La enfermedad suele ser mortal es originada por una bacteria llamada 'Burkholderia pseudomallei', que contagia a animales y a personas.
La bacteria o microorganismo habita naturalmente en el suelo y el agua de entornos tropicales.
Además, se propaga por el aire y entre animales o personas, aunque esto ocurre en raras ocasiones.
Síntomas
Los expertos dicen que es difícil de diagnosticar, porque sus síntomas son poco específicos.
La melioidosis puede llegar con fiebre, tos y dolor en el pecho y también afectar al sistema nervioso.
Lo extraño es que no había aparecido nunca en Norteamérica, según datos del Centro de Seguridad Alimentaria y Salud Pública de la Universidad Estatal de Iowa.
Nadie sabe cómo los pacientes se infectaron con la bacteria, ya que ni siquiera viajaron fuera de Estados Unidos recientemente.
Además, las cepas de los tres casos son parecidas.
Todo un misterio que se busca resolver.
Joya.life, Emegency.cdc, Cfsph.iastate, Rt.





